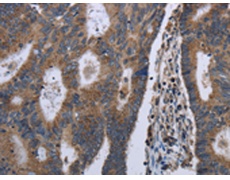
一抗

中文名稱:兔抗GSTA3多克隆抗體
英文名稱: Anti-GSTA3 rabbit polyclonal antibody
別 名: GTA3; GSTA3-3
相關(guān)類別: 一抗
抗 原: GSTA3
儲 存: 冷凍(-20℃)
宿 主: Rabbit
反應(yīng)種屬: Human
標(biāo)記物: Unconjugate
克隆類型: rabbit polyclonal
Background:
Cytosolic and membrane-bound forms of glutathione S-transferase are encoded by two distinct supergene families. These enzymes are involved in cellular defense against toxic, carcinogenic, and pharmacologically active electrophilic compounds. At present, eight distinct classes of the soluble cytoplasmic mammalian glutathione S-transferases have been identified: alpha, kappa, mu, omega, pi, sigma, theta and zeta. This gene encodes a glutathione S-tranferase belonging to the alpha class genes that are located in a cluster mapped to chromosome 6. Genes of the alpha class are highly related and encode enzymes with glutathione peroxidase activity. However, during evolution, this alpha class gene diverged accumulating mutations in the active site that resulted in differences in substrate specificity and catalytic activity.
Applications:
ELISA, WB, IHC
Name of antibody:
GSTA3
Immunogen:
Fusion protein of human GSTA3
Full name:
glutathione S-transferase alpha 3
Synonyms:
GTA3; GSTA3-3
SwissProt:
Q16772
ELISA Recommended dilution:
2000-5000
IHC positive control:
Human colon cancer and human liver cancer
IHC Recommend dilution:
50-200
WB Predicted band size:
25 kDa
WB Positive control:
Human testis tissue and HepG2 cells
WB Recommended dilution:
500-2000
技術(shù)規(guī)格


 購物車
購物車 幫助
幫助
 021-54845833/15800441009
021-54845833/15800441009